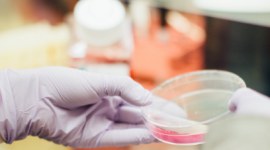
Codec Polska oraz ITP S.A., wdrożenie rozwiązania do controllingu.

Data publikacji: 2019-11-08
Oryginalny tytuł wiadomości prasowej: Codec Polska oraz ITP S.A., wdrożenie rozwiązania do controllingu.
Kategoria: BIZNES, IT i technologie
Codec Polska oraz ITP S.A. rozpoczynają wdrożenie rozwiązania do analiz zarządczych, controllingu i budżetowania. Nowy system wesprze dalszy rozwój firmy i dostarczy wartościowych informacji zarządczych.
Codec Polska oraz ITP S.A. rozpoczynają wdrożenie rozwiązania do analiz zarządczych, controllingu i budżetowania.
ITP SA specjalizuje się w selekcji najlepszych technologii i światowych marek w zakresie medycyny estetycznej, urządzeń medycznych i sprzętu wellness. Wdrożony system ma wspierać dynamiczny rozwój firmy i idący za tym wzrost potrzeb informacyjnych.
W ramach projektu zostanie zbudowane rozwiązanie usprawniające proces budżetowania, raportowania i analizy danych z poszczególnych spółek w zakresie rachunku wyników, bilansu i rachunku przepływów pieniężnych oraz szczegółowych analiz sprzedażowych.
Rozwiązanie będzie także wspierało obszar konsolidacji finansowej ze szczególnym uwzględnieniem procesu zbierania danych finansowych oraz eliminacji transakcji wewnętrznych.
System zostanie zbudowany w oparciu o platformę Infor d/EPM.
źródło: Biuro Prasowe
Załączniki:
Hashtagi: #BIZNES #IT i technologie